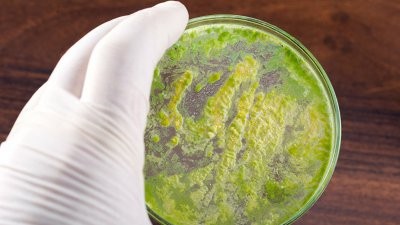
Пандемия коронавируса может вызвать распространение супербактерий

Пандемия коронавируса может вызвать распространение супербактерий

Пандемия коронавируса привела к тому, что люди с ослабленной иммунной системой поступают в больницы, которые являются местом размножения бактерий, устойчивых к лекарственным препаратов. Врачи опасаются, что излечившиеся распространят новые заболевания.
Читайте на Информинг. Ру Медики рассказали, как в короткие сроки повысить иммунитет
Есть данные, свидетельствующие о том, что во время пребывания в больнице у многих пациентов диагностируют вторичные инфекции. Источник и характер этих инфекций пока остается неизученным.
Но есть информация о том, что бактерии с устойчивостью к лекарствам входят в число микробов, вызывающих эти вторичные инфекции. Судя по всему, вторичные инфекции влияют на выживаемость пациентов. Половина всех умерших от коронавируса в Ухани имела вторичную инфекцию. Это обусловлено тем, что многие из этих больничных бактерий атакуют людей с ослабленным иммунитетом.
Если пациента подключить к аппарату ИВЛ, то риск заразиться инфекцией возрастает до 50%, отмечают ученые. Таким образом, реанимационное отделение может стать очагом заражения.
Практика показывает, что на уровень смертности от вирусных инфекций влияют вторичные бактериальные инфекции. Во время пандемии испанки в 1918 году и эпидемий гриппа в 2009 больше людей умерли не от самого вируса, а от вторичных инфекций.
Использование антибиотиков у пациентов с COVID-19 является еще одним фактором, который окажет влияние на кризис устойчивости к антибиотикам.
Новые данные говорят о том, что 90% пациентов с COVID-19 получают антибактериальное лечение. Увеличение использования антибиотиков будет способствовать росту заболеваемости лекарственно-устойчивыми инфекциями через годы после окончания пандемии. То есть, пандемия коронавируса может вызвать распространение супербактерий.
Однако медики уже стали изучать особенности применения антибиотиков у пациентов с коронавирусом. Так, Пентагон уже проводит исследование для отслеживания использования антибиотиков и частоты вторичных инфекций среди пациентов с COVID-19. Результаты исследований помогут определить, когда и как назначать антибиотики больным с коронавирусом.
Яндекс Дзен










